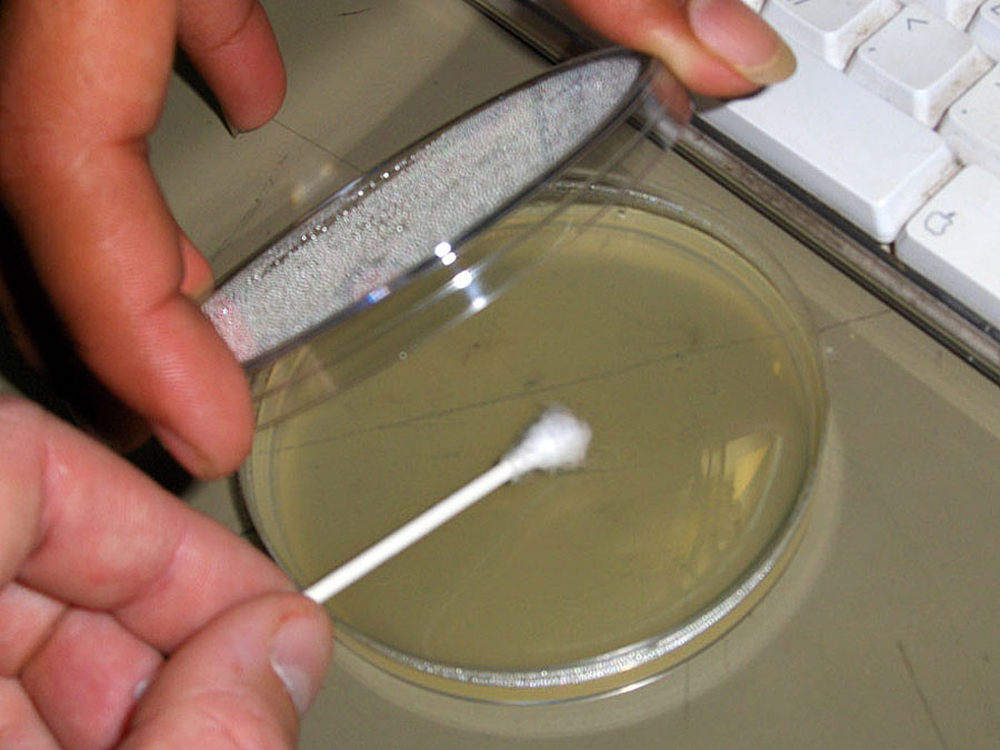
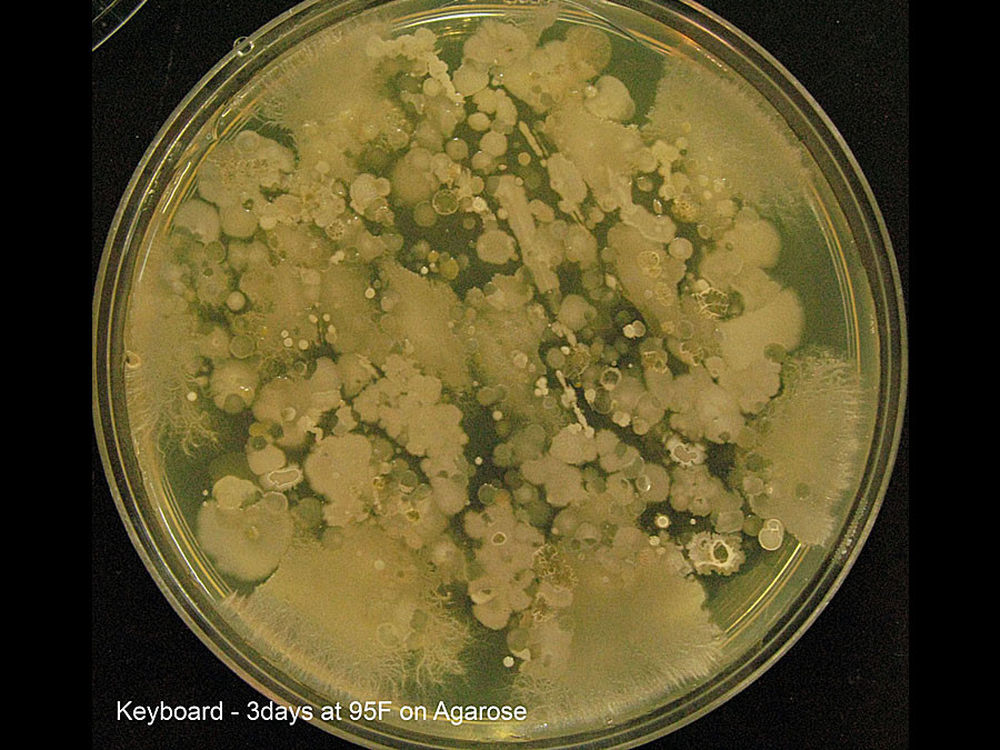
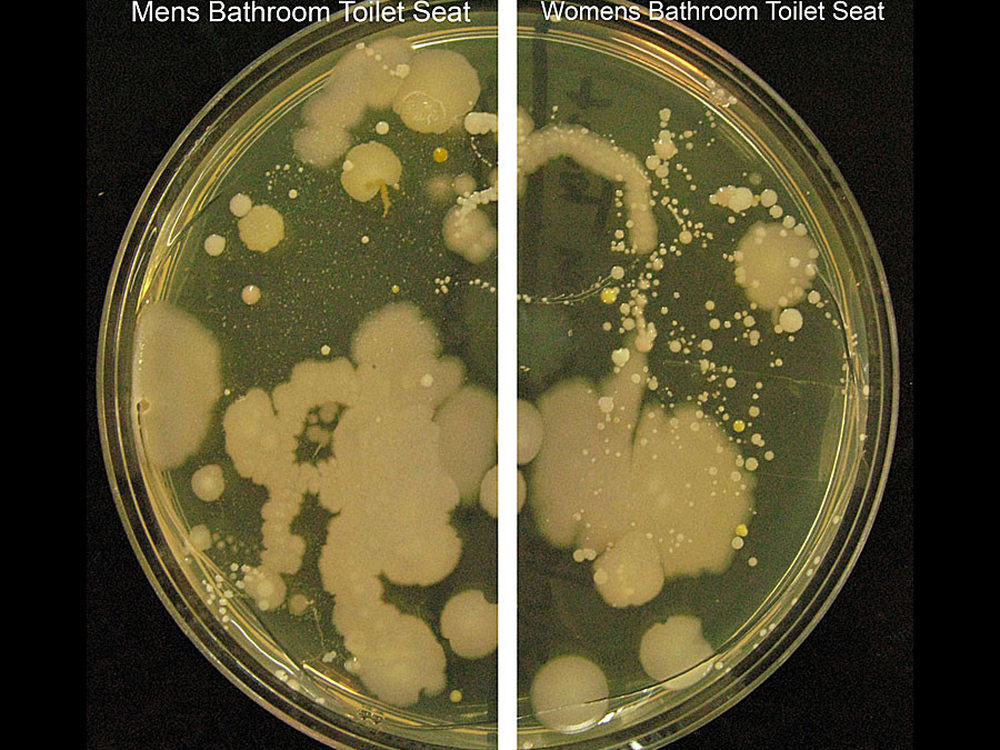

竟比马桶脏!手把手教你清理电脑键盘

1/15
前几天当小编听到朋友说“没想到2012就这么到了”的时候才恍然大悟——2012年真的来了。不管怎么样,新的一年到来,自然是要告别过去,面向未来,辞旧迎新。对于像小编这样整天跟电脑打交道的人来说,辞旧自然是要围绕电脑了,电脑的CPU、显卡、主板这些硬件小编不敢轻易“辞”掉,但对于键盘这样的硬件来说,小编当“辞”不让——挨了一年的敲打了,也该清理下了。
本文图片来自:instructables.com
2/15
首先就是要将自己的电脑键盘从主机上取下来,小编的建议是正式清理之前先将键盘反扣在桌面上,拍打下键盘背面,让那些瓜子壳、烟灰、饼干渣以及其他的不明物从键盘缝隙“倾倒”出来,对于那些桌面比较乱的人来说,这里用“倾倒”真的很合适。
3/15
然后就是要取下键盘的键帽了,如果没有专用工具,普通键盘可以用螺丝刀或者小刀等工具代替轻轻将键帽撬下来。
4/15
上图就是将键帽去掉后的键盘样子。
5/15
取下来的键帽。如果对每个按键的位置不是很熟悉的话,建议你将取下来的键帽按在键盘中的位置摆放好,以便清理完安装回去。
6/15
由于键帽本身结构问题,它的内部成了藏污纳垢的绝佳场所,如果你已经很长时间没清理过键盘,那么键帽里面的污垢量一定会让你大跌眼镜。
7/15
“宰相肚里能撑船”,键盘中最长的按键——空格键自然也能装下最多的污垢。
8/15
用棉球蘸水清理按键底座周围部分,可以使用酒精等有机溶剂去掉难以清理的油污。
9/15
每个键帽的表面可以像这样用纸巾清理,而键帽内部可以像上页一样采用棉签清理。
10/15
清理完后的空格键,看着要比原来舒服多了。
11/15
回车键是第二大藏污量的按键,清理完后也更干净了。
12/15
将所有的键帽安装回去,安装的时候要注意每个按键的位置以及方向。
13/15
番外篇:早有耳闻鼠标和键盘是电脑硬件中最脏的了,这里不妨做个实验,看看键盘到底有多脏。
用棉签刮一下清理前的按键,然后在培养皿中的培养基上蘸一下。
14/15
在适宜的温度和环境中,按键上的细菌在三天后成长为了菌落,菌落数量之多令人叹为观止。
15/15
为了方便对比,这里还采用同样方法观察了男女厕所马桶上的细菌量,其实跟键盘上的菌落量相比,这简直就是小巫见大巫了。因此,为了自己的身体健康,还是在新年之际好好清理下自己的键盘吧。